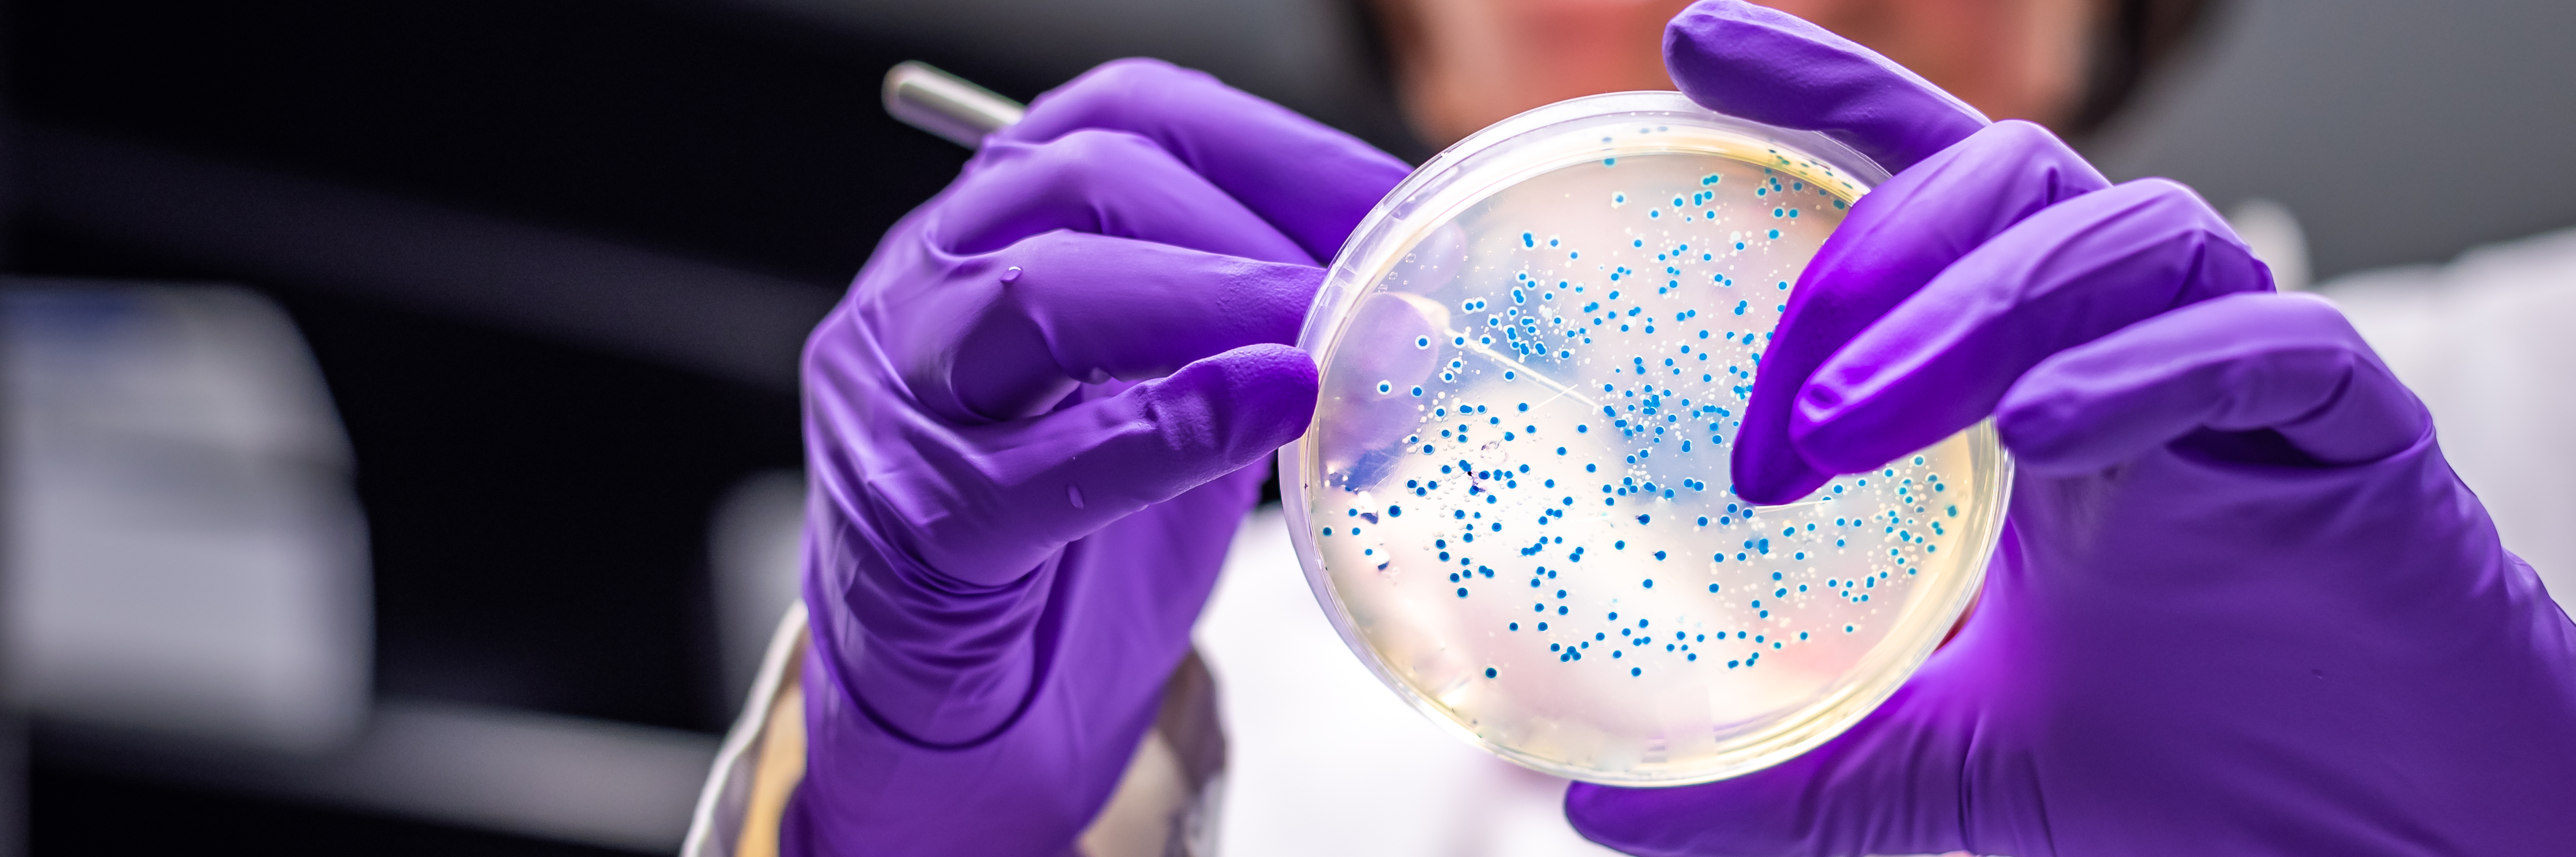

Cytopathology
Cytopathology is the branch of pathology that focuses on the study of individual cells from body tissues and fluids to detect diseases, infections, and cancer at an early stage. It is widely used in screening programs, early cancer detection, and monitoring treatment response.
Cytopathology is less invasive than traditional tissue biopsies and helps doctors make rapid, accurate diagnoses. Samples are usually obtained from body fluids, fine needle aspirations (FNA), Pap smears, sputum, urine, or other secretions.
Common Cytopathology Tests
- Pap Smear: Screening for cervical cancer and pre-cancerous changes.
- Fine Needle Aspiration Cytology (FNAC): Evaluates lumps or masses in organs like breast, thyroid, lymph nodes, liver, or lungs.
- Body Fluids Examination: Analysis of pleural, peritoneal, pericardial fluids to detect infections or malignancy.
- Urine Cytology: Detects bladder cancer and urinary tract abnormalities.
- Sputum Cytology: Screening for lung cancer and respiratory infections.
- CSF Cytology: Detects infections, malignancy, or inflammation in cerebrospinal fluid.
